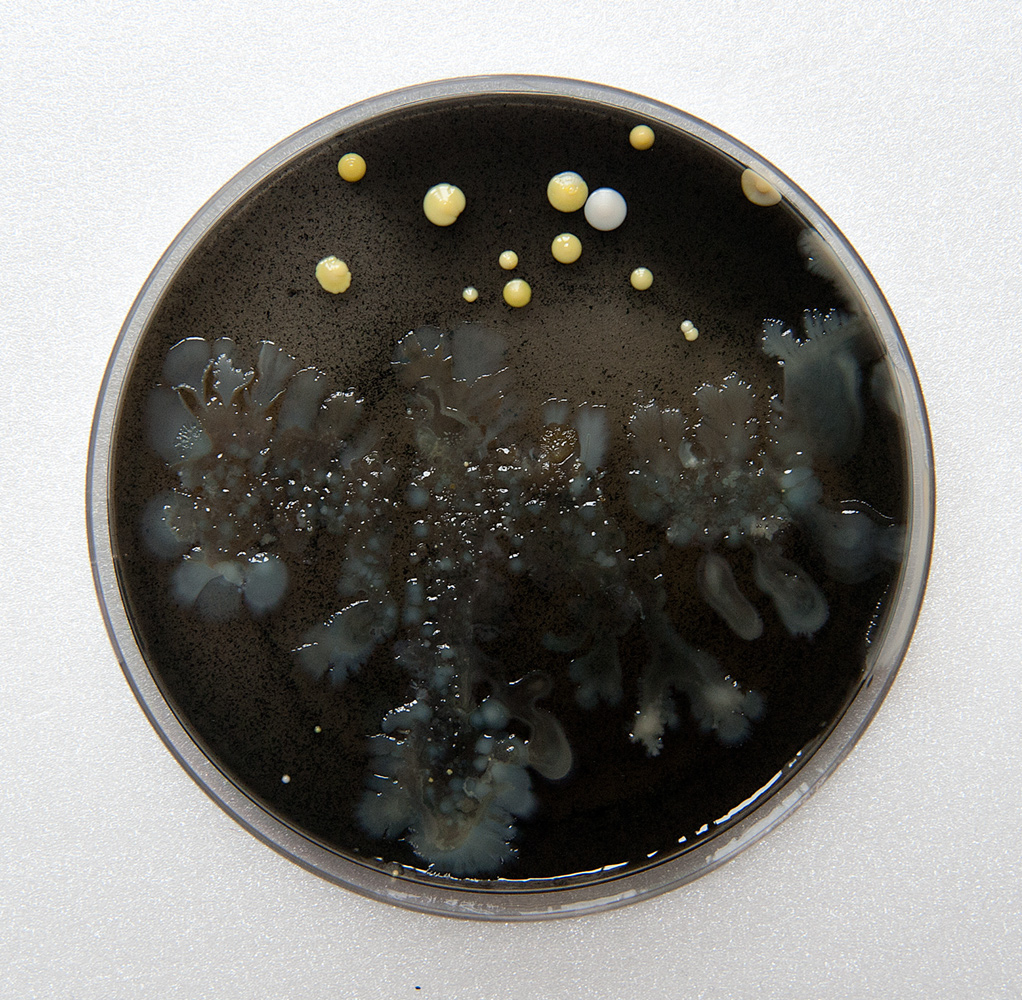

(2013-…)
Les Dispersions sont un corpus de travaux non sériels développés à l’origine pour l’exposition personnelle Disperse suite à une résidence à L’attrape-couleur (Lyon) en 2013, et qui constituent la matrice de mes recherches ultérieures. Il s’agit d’expérimenter différentes tactiques de fragmentation ou de dissolution dans la représentation des barrières territoriales. Si les premiers territoires concernés sont d’ordre politique – frontières urbaines et identitaires – cette réflexion s’étend également aux limites physiques de l’individu, et à la figuration de son rapport à l’espace.
Cette approche se traduit notamment par des jeux optiques visant à déconstruire l’imagerie stéréotypée des zones périurbaines : illuminations, dédoublements, reflets, projections… Ces expériences sont à l’origine des premières images la série de paysages sur miroir Fractal Spaces, mais également de l’installation Silently Blowing Almost Every Building on Rue de la Ligne de l’Est.
Avec Château Pétri, incubation et dispersion participative de bactéries commensales, c’est aussi le territoire corporel qui est questionné. Une démarche prolongée par la performance Les dérivants, collecte, mise en bouteille et à l’eau de projets avortés de soixante-deux artistes. La dispersion est ici pour moi une manœuvre d’évasion : choisie pour sortir des carcans de mon propre travail comme pour passer à travers les mailles des pouvoirs risquant de le figer.
Silently blowing almost every building on rue de la Ligne de l’Est
Une série de 23 photographies a été prise sur un lieu de mémoire répondant aux stéréotypes du périurbain: la rue de la Ligne de l’Est, à Villeurbanne, longe une ancienne voie ferrée ayant servi à la déportation en 1943, et est bordée de HLM et de friches industrielles laissant place à des immeubles de bureau en chantier. Ces images sont projetées en boucle sur un dispositif optique comprenant, sur un même axe, successivement une boule à facettes et un miroir mural. Elles sont ainsi retroprojetées sur le mur d’en face, leur centre étant oblitéré par l’ombre de la boule. Les informations masquées par cette ombre sont réfractées en multiples fragments mouvants à travers la pièce.
Château Pétri
Cinquante boîtes de pétri ont été ensemencées en bactéries commensales provenant du nombril de l’artiste et de trois autres personnes rencontrées en résidence : Jean-Baptiste Veyrieras, ingénieur bioinformaticien, Natacha Vignon, psychomotricienne, et Nicolas Zlatoff, directeur de troupe. Elles sont présentées en culture sur une table de lecture lumineuse en un carré évolutif. Chacune de ces Dispersées est proposée 10 € à la vente. Chaque vente enlève successivement une des huit pièces du carré – démantèlement symbolique d’un territoire – la boite ainsi dispersée étant remplacée par une autre. La somme que représenterait la vente de l’intégralité des boîtes équivaudrait à la subvention territoriale accordée à l’exposition Disperse.
Amoko
Culture de bactéries commensales de l’artiste dans trois boîtes de pétri, reproduisant sur gélose à l’encre de seiche le code morse SOS. La culture était évolutive pendant les trois semaines de l’exposition Little Big Crunch à Plateforme (Paris) en 2013.
Les dérivants
Mise à l’eau des projets en bouteille lumineuses (Leds, batteries biodégradables) de 62 artistes refusés ou non réalisés, collectés suite à un appel à participation libre. Le repêchage en aval de trois bouteilles a été signalé à ce jour, la dernière en 2018. Attrape-Couleur